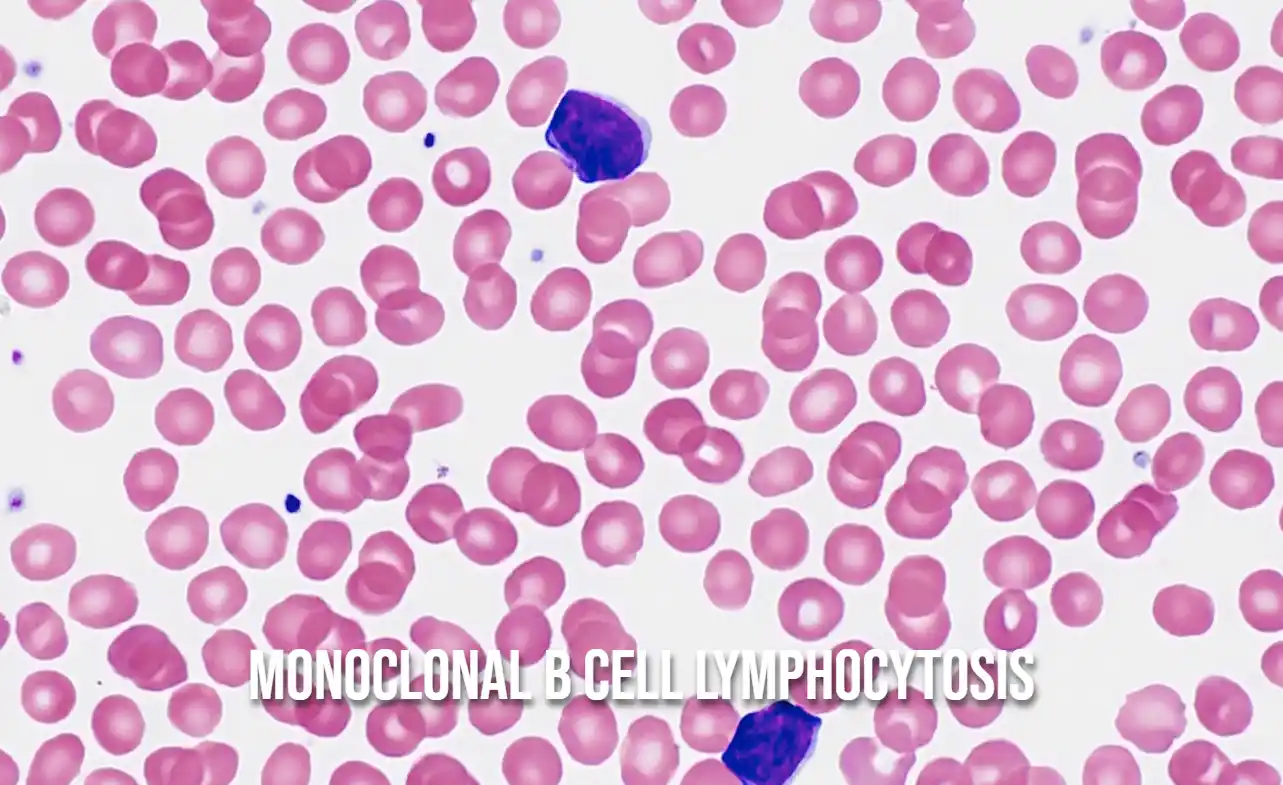

Stagescancer.net – Monoclonal B cell lymphocytosis (MBL) is a condition characterized by the presence of abnormal B cells in the blood. While often asymptomatic, MBL is a closely monitored condition due to the potential for progression to other diseases, including chronic lymphocytic leukemia (CLL).
In this comprehensive article, we delve into the nature of MBL, including its diagnosis, potential progression, and the latest research insights. Stay tuned to learn more about this intriguing condition and its implications for individuals.
Read on to explore the different types of MBL, diagnosis methods, risk factors for progression, and available treatment options. We also discuss the latest research findings and future directions in the field, providing you with a complete overview of this complex condition.
What is Monoclonal B Cell Lymphocytosis?
Monoclonal B cell lymphocytosis (MBL) is a condition characterized by the presence of abnormal B cells in the blood, which are a type of white blood cell that produces antibodies to help the body fight infection.
In MBL, these abnormal cells are present in the blood but do not cause any symptoms or require treatment. MBL is often detected during a routine blood test and may be an incidental finding.
MBL is considered a precursor to chronic lymphocytic leukemia (CLL), a type of cancer that affects the same type of cells as MBL. However, not all cases of MBL progress to CLL.
Types of Monoclonal B Cell Lymphocytosis
Monoclonal B cell lymphocytosis (MBL) is a disease that can have two different types: low-count MBL and high-count MBL. The main difference between the two types is the number of monoclonal B cells present in the blood. Low-count MBL is characterized by a lower number of malignant cells, typically less than 0.5 x 10^9/L. High-count MBL, on the other hand, is defined by a higher number of malignant cells, with a count of more than 0.5 x 10^9/L.
| Type of MBL | Characteristics |
|---|---|
| Low-count MBL | Less than 0.5 x 10^9/L monoclonal B cells in the blood |
| High-count MBL | More than 0.5 x 10^9/L monoclonal B cells in the blood |
While both types of MBL may have similar clinical presentation and exhibit the same molecular features, high-count MBL has a higher risk of progression to lymphoma or chronic lymphocytic leukemia, as compared to low-count MBL. It is also important to note that not all low-count MBL cases require treatment, and some may have stable disease for many years. Therefore, the type of MBL a patient has can impact their prognosis and potential treatment plan.
Diagnosis of Monoclonal B Cell Lymphocytosis
Monoclonal B cell lymphocytosis (MBL) can be diagnosed through various methods, including blood tests and flow cytometry. Blood tests can measure the number and type of cells in the blood, allowing healthcare professionals to identify abnormal cells associated with MBL.
Flow cytometry is a diagnostic method that analyzes individual cells for specific characteristics. It is particularly useful for detecting low levels of MBL and distinguishing abnormal cells from normal cells. In some cases, bone marrow biopsy may also be used to confirm an MBL diagnosis.
It’s important to note that MBL may not always require treatment, and some individuals may be monitored closely through regular check-ups or watchful waiting. However, early diagnosis is critical for those who may be at risk for disease progression.
Clinical Significance of Monoclonal B Cell Lymphocytosis
The clinical significance of monoclonal B cell lymphocytosis lies in its potential to progress to other diseases. While the condition is generally benign, individuals with high-count MBL have an increased risk of developing chronic lymphocytic leukemia (CLL) and other lymphoproliferative disorders. Research has identified several risk factors associated with MBL progression, including male gender, older age, and specific genetic abnormalities.
| MBL Risk Factors for Progression | References |
|---|---|
| Male gender | Rawstron et al, Blood, 2007 |
| Older age | Sher et al, Blood, 2010 |
| Genetic abnormalities | Döhner et al, N Engl J Med, 2000 |
While not all individuals with MBL will progress to more serious conditions, regular monitoring and follow-up are crucial in detecting any potential progression. As such, individuals with MBL are advised to undergo regular check-ups and watchful waiting, with initial intervention typically not recommended unless the patient displays disease progression or symptoms.
In summary, while MBL is considered to be a benign condition, its progression to other lymphoproliferative disorders should not be overlooked. By detecting and monitoring any potential progression, individuals with MBL can receive prompt intervention and management, ultimately leading to better long-term outcomes.
Risk Factors for MBL Progression
Monoclonal B cell lymphocytosis (MBL) is a condition characterized by the presence of abnormal B cells in the blood. While MBL is generally considered a benign condition, it can progress to other diseases, including chronic lymphocytic leukemia.
Various risk factors may contribute to the progression of MBL. One of these is genetic predisposition. Studies have shown that individuals with a family history of MBL or other blood cancers are at an increased risk of developing MBL.
Another potential risk factor is immune system dysfunction. Research suggests that individuals with weakened immune systems may be more susceptible to developing MBL and other blood cancers.
Factors That May Increase the Risk of MBL Progression
| Factor | Description |
|---|---|
| Age | Older adults are more likely to develop MBL and are at a higher risk of disease progression. |
| Gender | Research suggests that men may be more susceptible to developing MBL than women. |
| Environment | Exposure to certain environmental toxins and radiation may increase the risk of developing MBL. |
| Other medical conditions | Individuals with other medical conditions, such as autoimmune disorders, may be at an increased risk of developing MBL. |
It is important to note that not all individuals with MBL will develop other diseases, and the rate of disease progression can vary greatly between individuals. Regular monitoring and follow-up with a healthcare provider are crucial for individuals diagnosed with MBL to ensure prompt detection of any disease progression and appropriate intervention, if necessary.
Monitoring and Follow-Up for Monoclonal B Cell Lymphocytosis
Individuals with monoclonal B cell lymphocytosis (MBL) require ongoing monitoring and regular check-ups to ensure early detection of any progression of the disease. MBL is a condition that can remain stable for years or even decades without causing any symptoms. However, it can potentially evolve into other conditions, such as chronic lymphocytic leukemia, a type of blood cancer.
During regular check-ups, healthcare professionals may conduct various tests, such as blood tests and bone marrow biopsies, to monitor any changes in the MBL progression. These tests can help identify any signs of disease progression before the onset of symptoms. Although there is no specific treatment for MBL, early detection can help ensure that appropriate treatment is administered promptly in the event of disease progression.
The concept of watchful waiting is common for individuals with MBL who have a low risk of developing other conditions. This approach involves close monitoring of the MBL and not initiating treatment unless the disease progresses. This is because many individuals with low-count MBL never progress to another condition. The healthcare team will carefully monitor the individual’s condition and only recommend a treatment plan when necessary.
Monitoring and follow-up recommendations for MBL
| MBL Type | Frequency of Monitoring |
|---|---|
| Low-Count MBL | Annual check-ups with blood tests and physical exams |
| High-Count MBL | More frequent follow-ups, such as every 3-6 months with blood tests and other diagnostic exams as needed |
| Progressive MBL | Individualized treatment plan and frequent monitoring to evaluate the effectiveness of the treatment |
Regular monitoring and follow-up for MBL can help ensure the timely detection and management of the disease. MBL is a condition that requires ongoing medical attention and support, and the healthcare team should work closely with the individual to ensure their care is tailored to their specific needs.
Treatment Options for Monoclonal B Cell Lymphocytosis
Treatment for monoclonal B cell lymphocytosis (MBL) typically involves watchful waiting and regular monitoring by a healthcare professional to detect any progression of the disease. As MBL is a relatively benign condition, treatment is not necessary for most individuals unless the disease progresses.
In some cases, participation in clinical trials may be an option for those with MBL, particularly those with high-count MBL or genetic abnormalities associated with disease progression.
It’s essential to note that there is currently no standard treatment regimen for MBL, and treatment decisions should be made on a case-by-case basis in consultation with a healthcare professional.
Latest Research Insights on Monoclonal B Cell Lymphocytosis
Advancements in MBL research continue to provide breakthroughs and insights into the disease. Recent studies have focused on identifying predictive markers and improving diagnostic techniques to detect and monitor MBL more effectively. One such study found that mutations in certain genes are associated with an increased risk of MBL progression to chronic lymphocytic leukemia (CLL). Another study showed that the use of next-generation sequencing can identify clonal evolution in MBL, providing a more comprehensive understanding of the disease.
Further research has also explored potential treatment options for MBL, including the use of monoclonal antibodies and immunotherapy. Clinical trials are underway to investigate the efficacy of these treatments and their potential impact on disease progression.
In summary, the latest MBL research provides hope for improved diagnosis, monitoring, and treatment options for individuals with this disease. Ongoing studies continue to push the boundaries of our understanding and pave the way for future breakthroughs.
Prognosis of Monoclonal B Cell Lymphocytosis
Monoclonal B cell lymphocytosis, or MBL, is a condition that is increasingly being diagnosed due to advances in medical technology. While it is a benign condition, MBL may also develop into a more serious form of lymphocytic leukemia over time. As a result, the prognosis for MBL varies depending on several factors, including personal health history, genetic predisposition, and lifestyle.
Disease Outcomes
The potential disease outcomes for individuals with MBL can be highly variable. Some individuals may never progress to a more serious form of lymphocytic leukemia and may live a long and healthy life without major complications. However, others may experience disease progression and may require ongoing monitoring, medical intervention, and treatment.
Doctors typically use a variety of factors to determine an individual’s overall risk of disease progression, including the number of abnormal cells present in the blood, the size of an individual’s blood and bone marrow cells, and overall health and immune function.
Long-Term Effects
The long-term effects of MBL can also vary depending on individual patient factors. While some individuals may experience little to no long-term effects from MBL, others may experience chronic symptoms such as fatigue, weakness, and lymph node swelling. In addition, some individuals may be at a higher risk for developing other diseases or complications, such as infections and autoimmune disorders.
| Moderate Risk Factors | High-Risk Factors |
|---|---|
| Older Age | High MBL cell counts |
| Male Gender | Abnormal chromosomes in cells |
| Family History of Leukemia | Immunodeficiency or autoimmune disorders |
It is important for individuals with MBL to have regular checkups and to work closely with their healthcare provider to monitor the condition and manage any potential complications.
Lifestyle and Management Strategies for Monoclonal B Cell Lymphocytosis
Monoclonal B cell lymphocytosis (MBL) is a condition that requires careful management to maintain good health and reduce the risk of progression to other diseases. Individuals with MBL can take proactive steps to improve their overall well-being, including healthy lifestyle habits and stress reduction techniques.
Healthy Habits
Adopting healthy habits can help individuals with MBL improve their immune system function and overall wellness. This includes maintaining a balanced diet with plenty of fruits, vegetables, and whole grains, staying hydrated, and engaging in regular physical activity.
Stress Reduction Techniques
Stress can negatively impact overall health, including immune system function. Effective stress reduction techniques, such as exercise, meditation, and deep breathing exercises, can help manage stress levels and improve overall well-being.
Regular Check-Ups
Individuals with MBL should have regular check-ups with their healthcare provider to monitor their condition and ensure early detection of any potential complications. This may include regular blood tests and imaging studies.
Participation in Clinical Trials
Participation in clinical trials may be an option for individuals with MBL. These trials can provide access to cutting-edge treatments and medications, as well as advance the overall understanding of the condition.
Support and Resources for Monoclonal B Cell Lymphocytosis Patients
Being diagnosed with monoclonal B cell lymphocytosis (MBL) can be overwhelming and stressful. To help individuals manage their condition, there are several support networks and resources available.
Patient Resources
There are numerous patient resources available online for individuals with MBL. These resources may offer a wealth of information on MBL diagnosis and treatment options, as well as coping strategies and lifestyle management techniques. Examples of patient resources include:
- The Leukemia & Lymphoma Society
- The Lymphoma Research Foundation
- The National Comprehensive Cancer Network
Support Groups
Support groups can be instrumental in providing emotional support and advice to individuals with MBL. These groups may be offered by local hospitals or cancer centers, and they typically offer opportunities for individuals with MBL to connect with others who are going through similar experiences. Support groups can be a valuable source of information on MBL management and may help individuals feel less isolated and more supported.
MBL Support
Numerous organizations offer MBL support, such as the MBL International Working Group, which works to raise awareness about MBL and provides support to individuals with the condition. Additionally, many hospitals and cancer centers have specialized MBL clinics that can provide expert care and support to individuals with MBL.
By taking advantage of these resources, individuals with MBL can gain the knowledge, support, and tools necessary to manage their condition and improve their quality of life.
Potential Complications of Monoclonal B Cell Lymphocytosis
While monoclonal B cell lymphocytosis (MBL) often presents no immediate health risks, this condition can occasionally result in complications. Disease progression is one of the most concerning potential complications of MBL, as this condition may transform into chronic lymphocytic leukemia (CLL) or lymphoma over time.
Individuals with MBL and certain subtypes of MBL have a higher risk of developing these conditions than others, and regular monitoring is crucial in these cases. Additionally, treatment-related complications can arise from attempts to manage MBL. For example, chemotherapy may cause unintended side effects, such as fatigue, infection, and hair loss.
However, it is important to note that not all individuals with MBL will experience complications. Each case is unique, and careful monitoring and an informed approach to treatment can reduce the risk of adverse outcomes.
Comparative Analysis of Monoclonal B Cell Lymphocytosis and Related Conditions
Monoclonal B cell lymphocytosis (MBL) is a precursor condition to chronic lymphocytic leukemia (CLL) and is characterized by the abnormal proliferation of B cells in the bloodstream. Although MBL shares many similarities with CLL, there are some key differences to be aware of.
MBL vs. CLL
| MBL | CALL | |
|---|---|---|
| Cell Count | Less than 5000 | 5000 or more |
| Lymph Nodes | Normal | Enlarged |
| Bone Marrow | Normal | Infiltrated with malignant cells |
| Progression to CLL | Potential | Common |
As seen in the table above, MBL is often diagnosed in individuals with a lower cell count, whereas CLL typically presents with a higher cell count and the infiltration of malignant cells into the bone marrow. Additionally, CLL commonly leads to the enlargement of lymph nodes, which is not typically seen in MBL. However, MBL does have the potential to progress to CLL over time.
By comparing MBL to related conditions like CLL, a deeper understanding of MBL can be gained. This comparison highlights the similarities and differences between MBL and other conditions, helping healthcare professionals provide a more accurate diagnosis and effective treatment plan.
Future Directions in Monoclonal B Cell Lymphocytosis Research
As research into monoclonal B cell lymphocytosis (MBL) advances, emerging treatments are being explored to improve patient outcomes. One promising area of research is the development of predictive markers, which could help identify individuals at risk of disease progression.
Currently, the standard approach to MBL management is watchful waiting. However, there are several clinical trials underway to investigate new treatment options, such as immunotherapy and targeted therapies.
Emerging Treatments for MBL
Immunotherapy treatments use the body’s immune system to fight cancer cells. One type of immunotherapy being studied in MBL is monoclonal antibodies, which target specific proteins in cancer cells, triggering the immune system to attack them. Another promising treatment is chimeric antigen receptor (CAR) T cell therapy, which involves genetically modifying a patient’s T cells to recognize and attack cancer cells.
Targeted therapies are another type of treatment being explored in MBL. These medications block specific molecules that are involved in cancer cell growth and survival. One targeted therapy being studied is ibrutinib, a drug that inhibits a protein called Bruton’s tyrosine kinase, which is important for B cell growth and survival. Another targeted therapy being studied in MBL is venetoclax, which blocks a protein called B-cell lymphoma 2 (BCL-2), promoting cancer cell death.
Predictive Markers for MBL Progression
Currently, there are no reliable predictive markers for MBL progression. However, researchers are studying various biomarkers that may be associated with disease progression, including chromosomal abnormalities and immune system markers.
-table-
Ongoing Clinical Trials in MBL Treatment
Treatment Type Drug Name Phase/Status Monoclonal antibody MOR208 Phase II BTK inhibitor Ibrutinib Phase II BCL-2 inhibitor Venetoclax Phase II CAR T cell therapy CTL119 Phase I/II Dual BTK and PI3K inhibitor Umbralisib Phase I/II
It is important to note that these emerging treatments are still in the early stages of research and clinical trials. Further studies are needed to determine their effectiveness and potential side effects.
Overall, the future of MBL research holds promise for the development of new treatments that may improve patient outcomes. The identification of predictive markers may also help identify individuals at risk of disease progression and enable early intervention.
Conclusion
Monoclonal B cell lymphocytosis (MBL) is a condition that involves the presence of abnormal B cells in the blood. While MBL may not cause any symptoms or require treatment, it is essential to monitor the condition regularly.
Key takeaways from this article include the types of MBL, diagnosis methods, clinical significance, and potential progression, risk factors for progression, monitoring and follow-up strategies, treatment options, prognosis, lifestyle and management strategies, support and resources available, potential complications, a comparative analysis with related conditions such as chronic lymphocytic leukemia, and future directions in research exploring emerging treatments and predictive markers.
Individuals with MBL should work closely with their healthcare providers to determine the best course of action for their condition. With the latest research insights, advancements, and breakthroughs in the field, it is essential to stay informed about MBL and its potential impact on long-term health outcomes.
In conclusion, while MBL can be a challenging condition to navigate, there are strategies available for managing the condition effectively. With an informed approach and access to the right resources, individuals with MBL can take an active role in their health and well-being.
FAQ
What is monoclonal B cell lymphocytosis?
Monoclonal B cell lymphocytosis (MBL) is a condition characterized by the presence of an abnormal number of B cells in the blood. It is considered a precursor to certain types of blood cancers, such as chronic lymphocytic leukemia (CLL).
What are the different types of monoclonal B cell lymphocytosis?
There are two main types of monoclonal B cell lymphocytosis: low-count MBL and high-count MBL. Low-count MBL is when the abnormal B cells represent less than 5% of the total lymphocytes, while high-count MBL is when the abnormal B cells represent 5% or more of the total lymphocytes.
How is monoclonal B cell lymphocytosis diagnosed?
The diagnosis of monoclonal B cell lymphocytosis is typically made through blood tests and flow cytometry. These tests help identify and quantify the abnormal B cells in the blood sample.
What is the clinical significance of monoclonal B cell lymphocytosis?
Monoclonal B cell lymphocytosis carries clinical significance due to its potential progression to other diseases, particularly CLL. However, not all individuals with MBL will develop CLL or other blood cancers.
What are the risk factors for monoclonal B cell lymphocytosis progression?
Risk factors for the progression of monoclonal B cell lymphocytosis include genetic predisposition, a family history of CLL or other blood cancers, and immune system dysfunction.
How should monoclonal B cell lymphocytosis be monitored and followed up?
Individuals diagnosed with monoclonal B cell lymphocytosis should undergo regular check-ups to monitor any changes in their condition. This monitoring approach, often referred to as watchful waiting, involves observing the progression of the disease without initiating treatment unless necessary.
What are the treatment options for monoclonal B cell lymphocytosis?
Currently, there is no standard treatment for monoclonal B cell lymphocytosis. Watchful waiting is often recommended for individuals with low-risk MBL. However, participation in clinical trials may be an option for those with high-risk MBL or specific features that indicate a higher likelihood of progression.
What are the latest research insights on monoclonal B cell lymphocytosis?
Ongoing research in the field of monoclonal B cell lymphocytosis aims to better understand the disease’s underlying mechanisms, identify predictive markers for progression, and explore potential targeted therapies.
What is the prognosis of monoclonal B cell lymphocytosis?
The prognosis of monoclonal B cell lymphocytosis varies from individual to individual. While some individuals may experience disease progression and develop CLL or other blood cancers, others may remain stable with no significant health issues.
Are there lifestyle and management strategies for individuals with monoclonal B cell lymphocytosis?
Yes, incorporating healthy habits such as regular exercise, a balanced diet, and stress reduction techniques can contribute to overall well-being for individuals with monoclonal B cell lymphocytosis. It is also essential to follow medical advice and adhere to recommended follow-up appointments.
Are there support and resources available for monoclonal B cell lymphocytosis patients?
There are various support and resources available for individuals diagnosed with monoclonal B cell lymphocytosis. These include patient resources provided by healthcare institutions, educational materials, and support groups where individuals can connect with others going through a similar experience.
What are the potential complications of monoclonal B cell lymphocytosis?
Potential complications of monoclonal B cell lymphocytosis include disease progression to CLL or other blood cancers and treatment-related complications. However, it is important to note that not all individuals with MBL will experience these complications.
Monoclonal B cell lymphocytosis is often compared to other related conditions, such as chronic lymphocytic leukemia (CLL). Understanding the similarities and differences between these conditions can help provide a clearer picture of the disease and its progression.
What are the future directions in monoclonal B cell lymphocytosis research?
Future research in monoclonal B cell lymphocytosis aims to uncover further insights into the disease’s biology, develop novel treatment approaches, and identify predictive markers to better assess the risk of progression.
What are the key takeaways from our exploration of monoclonal B cell lymphocytosis?
Monoclonal B cell lymphocytosis is a condition characterized by the presence of abnormal B cells in the blood. It can potentially progress to CLL or other blood cancers, although not all cases will lead to disease progression. Regular monitoring, lifestyle management, and accessing available resources are important aspects of managing the condition.